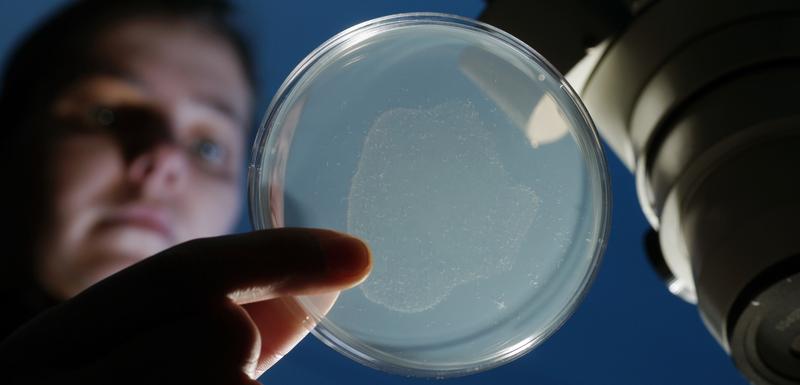

What makes a small worm a popular model
Researchers from the Friedrich Schiller University Jena and Kiel University have compiled all metabolic pathways of the model organism Caenorhabditis elegans described so far and have presented a comprehensive metabolic model in the current edition of the journal "Cell Systems". The model, called "ElegCyc", covers about 2,000 metabolic processes and is available to research groups all over the world.
It is only about one millimetre long and therefore barely visible with the naked eye. Its brief existence of only two to three weeks is spent hidden in the soil. At first glance, the tiny worm Caenorhabditis elegans and humans have very little in common. And yet their genetic make-up shows amazing similarities: "Up to 80 percent of the genes of the worm and humans are the same", says Dr Christoph Kaleta, bioinformatics scientist from Kiel, Professor of Medical Systems Biology at the Faculty of Medicine at Kiel University and a member of the Cluster of Excellence "Inflammation at Interfaces". "Approximately half of all the known genes which are involved in human diseases can also be found in C. elegans." This is the reason why the worm can be used as a simple model system to investigate and gain a better understanding of life processes as well as diseases – also in humans.
To help in this endeavour, Kaleta and his team together with colleagues from the Friedrich Schiller University Jena and ETH Zürich have summarised the worm's complete metabolism in a mathematical model. Thus, all its metabolic pathways can be tracked "in silico" (on the computer) and investigated. "In particular, we are also able to forecast how certain changes – such as in food absorption – affect growth, life expectancy or the occurrence of diseases in this organism", explained Kaleta, who carried out research and lectured as an assistant professor at the University of Jena until 2014. Together with his former working group and gerontologists from Jena and Zurich, he presented the model called "ElegCyc" in the latest edition of the scientific journal "Cell Systems" (DOI: 10.1016/j.cels.2016.04.017).
The researchers combed through databases and specialist literature in meticulous detail and combined all the metabolic pathways of C. elegans that have been described up to now. In total, almost 2,000 metabolic processes were recorded in this way and linked to each other. A complex network emerged that shows the worm's life processes in detail and which the scientists can now search for individual genes, metabolic products or reactions. The major advantage of such comprehensive computer models is that they also enable the analysis of enormous amounts of data, says Juliane Gebauer from the Chair of Bioinformatics at the University of Jena. "Modern high-throughput techniques, such as RNA sequencing or metabolomics provide such a plentiful supply of data, which can hardly be analysed comprehensively without such models", says the doctoral candidate, who is the lead author of the publication.
The bioinformatics scientists were able to show that their model satisfies these requirements in the study that has now been presented: They fed the model with experimental data on the ageing process from the Jena research centre JenAge. The worms were given three different substances to eat, two of which were known to extend their lifespan. The activity of the roughly 20,000 genes of C. elegans was determined at a total of four points in time. Thanks to the "ElegCyc" model, the researchers identified which metabolic processes among this large number of genes contributed to the lifespan-extending effect of the fed substances.
In their future studies, the researchers want to use their model to gain a better understanding of the interaction between the worm and its intestinal bacterial microbiome. In contrast to the highly complex microbiome of humans, the worm’s microbiome is very simple, making it particularly suitable to investigate how certain species of bacteria benefit health or promote diseases. From these studies, the researchers hope to gain new insights into the occurrence of chronic inflammatory bowel diseases, which are accompanied by a major imbalance in the intestinal microbiome in humans.
The metabolic model of C. elegans is freely accessible on the Internet at: http://elegcyc.bioinf.uni-jena.de:1100
Original publication:
Gebauer et al., A Genome-Scale Database and Reconstruction of Caenorhabditis elegans Metabolism, Cell Systems (2016), http://dx.doi.org/10.1016/j.cels.2016.04.017
Contact:
Juliane Gebauer
Chair of Bioinformatics at the Friedrich Schiller University of Jena
Ernst-Abbe-Platz 2, 07743 Jena
Tel.: +49 (0)3641 / 949594
E-mail: juliane.gebauer[at]uni-jena.de
Prof. Dr. Christoph Kaleta
Cluster of Excellence "Inflammation at Interfaces" and the Institute of Experimental Medicine at the Christian Albrechts University Kiel
Michaelisstr. 5, Haus 17, 24105 Kiel
Tel.: +49 (0)431 / 5973046
E-mail: c.kaleta[at]iem.uni-kiel.de
Weitere Informationen:
http://www.uni-jena.de
http://www.uni-kiel.de
Die semantisch ähnlichsten Pressemitteilungen im idw